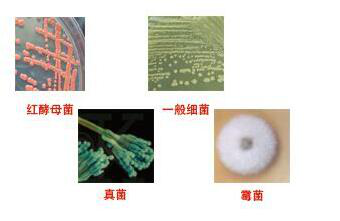
金色隐球酵母直销

- 详细信息
- 文献和实验
- 技术资料
- 库存:
51
- 英文名:
Cryptococcus│aureus
- 保质期:
详见说明书
- 供应商:
上海西格
- 保存条件:
2-8℃冷藏
- 规格:
详见说明书
( 1 )金色隐球酵母直销通过灌根可有效防治植物细菌性和真菌性土传病害,同时可使植物叶部的细菌和真菌病害明显减少;
( 2 )对植物具有明显的促生长、增产作用。 多粘类芽孢杆菌对细菌性土传病害 ―― 植物青枯病具有很好的防治效果,在收获后期,对番茄、茄子、辣椒、烟草、马铃薯、罗汉果和生姜青枯病(姜瘟病)的田间防效可达 70 ~ -- %,*增产率达 493 %,甚至当对照发病率高达 -- %时防效也是如此。 多粘类 芽孢杆菌 对芋头软腐病、大白菜软腐病、辣椒 根腐病 、花卉根腐病、玉竹根腐病、沙参根腐病、番茄猝倒病、番茄立枯病以及辣椒疫病等土传 病害 也具有较好的防治作用。 此外,多粘类芽孢杆菌对 植物 具有明显的促生长作用,可使田间植株高度比空白对照区增加 10-30cm ;甚至在植物不发青枯病时,也可使植物的产量增加 27.5% ,且增产主要表现为收获前期。
资源名称 金色隐球酵母直销
种属 Cryptococcus│aureus
分离基物 沉积物/表层沉积物
提供形式 斜面培养物
安全等级 1
模式菌株 no
应用领域 生物转化微生物/蛋白含量高
培养方法
培养基 513
生长条件 28℃
存储条件 液氮超低温冻结法;-80℃冰箱冻结法

菌种保藏方法及注意事项:
1传代保藏
传代保藏菌种是微生物保存中最常用的方法之一。很多微生物在低温或者干燥处理时,会很快死亡,为了保存菌种的活性,就要定期不断的进行菌种转接、培养后再保存。我们所喝的酸奶就是采用这种方式进行菌种保存的。这种会产生酸性物质的菌种,在进行传代培养时要在培养基中添加少量的碳酸钙。传代培养的过程中,培养的养分不要太丰富,培养温度也要比孢子最适合的生长温度略低。传代培养保存微生物的方法简单易行,只要培养皿就能实现,不需要特殊的设备,是目前实验室各类微生物保藏最常用的方法。但是此法也存在着一些缺点,如培养基容易干枯;菌种管处经常被其他杂菌污染发生霉变;菌种在反复传代的过程中发生基因突变,不能保证优良性状传递下来;在传代的过程中产生的孢子活性越来越弱。
2液体石蜡覆盖保藏
为了传代保存时,减少杂菌的侵染,使用液体石蜡进行覆盖加以辅助,就是在斜面培养基上,当在最适合的培养条件下培养出健壮的菌体后,加入已灭菌的液体石蜡油,并将此斜面培养基保藏在低温条件下。由于培养物表面覆盖液体石蜡后可隔绝空气,因此降低了微生物菌体的物质代谢,延缓细胞的衰老,同时也防止培养基水分蒸发,是一种简易的菌种保藏方法。很多产生孢子能力低的丝状菌都是采用这种方法进行保存。这种方法制作方法简单,不需要经常移种传代。对大多数种类的菌种保藏效果都比较理想。霉菌、放线菌、芽孢细菌可保藏2年以上,没有芽孢的细菌都可以采用这种方法保藏1年左右,一些很难保藏的菌种如脑膜炎球菌,可以的采用这种方法保存至少3个月以上。但是采用石蜡覆盖保藏法的菌种携带不方便,保存时需要大量空间,以保证培养基能直立放置。在取培养物进行移种时,一般要通过火焰灼烧将石蜡融化,这个过程可能造成培养物与石蜡油飞溅,有安全隐患。
3冷冻干燥保藏
冷冻干燥保藏法为菌种保藏方法中最有效的方法之一,对一般生活力强的微生物及其孢子以及无芽胞菌都适用。这种方法适用于菌种长期保存,一般可保存数年至十余年。因为冷冻干燥法使菌种处于一个无氧的真空环境中,微生物不能进行正常的新陈代谢,只能处于休眠状态。当环境变为适合生长的适合,才会继续增殖生长。所以保藏期就比较长。目前像春雷霉素、头孢霉素、卡那霉素等抗生素菌种不易产生孢子的丝状真菌,都是采用冷冻干燥法保存的。另外我国大多数生物制品菌种都是采用该法保藏。
4液氮超低温保藏
液氮超低温保藏法是菌种长期保藏的最有效最可靠的方法。液超低温保藏法是把菌种装在含有冷冻保护剂的安瓶瓶内,将该安瓶瓶放人液氮(-196℃)中保藏。由于菌丝体处于-196℃,其代谢降低到完全停止的状态。甘油、血清蛋白、二甲基亚砜、聚乙烯氮戊环、糊精、吐温80等可用做液氮低温保藏法的保护剂,其中甘油在进入和游出细胞时速度非常缓慢,造成强烈的脱水,从而保护细胞,是目前最常用的保护剂。不同微生物要选择不同的保护剂,再通过实验加以确定保护剂的浓度,原则上是控制在不足以造成微生物致死的浓度,一般甘油为10%-20%、二甲基亚砜为5%-10%、聚乙烯氮戊环为0.4mmol/L。
5蒸馏水保藏
蒸馏水保藏菌种的方法普遍的应用于医学微生物、食品微生物和工业微生物中,如皮肤癣菌、酵母、霉菌、放线菌的保藏,在食用菌金针菇的保藏中也有提到。其方法是:将菌体悬浮于蒸馏水中,即可在室温下保存数年,此法应注意避免水分的蒸发。
以下是公司正在热销的产品:
猪流感病毒通用型(SIV-U)核酸检测试剂盒(PCR-荧光探针法) 48T Stigmast-5-ene-3β,7α,16β-triol 289056-24-2 中文名: 分子式:C29H50O3 度:93.0% 关键词: 云南崖摩; 豆甾烷; 植物提取物; 天然产物; 天然产物库
猪流感病毒通用型(SIV-U)核酸检测试剂盒(-PCR法) 48T Stigmast-5-ene-3β,7α,16β-triol 289056-24-2 中文名: 分子式:C29H50O3
猪流感病毒Aelisa试剂盒 猪流感病毒A试剂盒 规格型号:96T/48T 猪流感病毒A试剂盒,规格型号:96T/48T,来源:elisa试剂盒(进口分装),产品别名:猪流感病毒A试剂盒、猪流感病毒A elisa试剂盒 保存条件:2-8℃ 保质期:6个月。 Benzofuroxan 中文名:苯并呋咱 分子式:C6H4N2O2
猪流感病毒A(FLUA)ELISAKit ELISA. 96T/48T Stigmasta-4,22,25-trien-3-one 848669-09-0 中文名: 分子式:C29H44O 度:% 关键词: 豆甾烷; 植物提取物; 天然产物; 天然产物库
猪链球菌通用型(SS-U)核酸检测试剂盒(PCR-荧光探针法) 48T Stanolone 521-18-6 中文名:雄诺龙 分子式:C19H30O2
N-(4-Cyanophenyl)glycine 中文名: 分子式:C9H8N2O2 猪α干扰素(IFN-α)ELISA试剂盒 96T/48T 试剂盒 组装/原装
N-(2-Methyl-5-nitrophenyl)-4- (pyridin-3-yl)pyrimidin-2-amine 中文名: 分子式:C16H13N5O2 猪α干扰素(IFN-α)ELISA试剂盒 96T/48T 试剂盒 组装/原装
N-(2-methyl-4-oxopentan-2-yl)-sulfamethoxazole 中文名: 分子式:C16H21N3O4S 猪S-100B蛋白(S-100B)ELISA试剂盒 96T/48T 试剂盒 组装/原装
N-(2-Hydroxyethyl)-3-(4-nitrophenyl)propylamine 中文名: 分子式:C11H16N2O3 猪β干扰素(IFN-β/IFNB)ELISAKit ELISA. 96T/48T
N-(2,6-Dimethylphenyl)-2-piperidinecarboxamide 中文名: 分子式:C14H20N2O 猪食欲素受体(OXR)ELISAKit ELISA. 96T/48T
异海松烯,二醇 HPLC≥98% 5mg Rat macrophage inflammatory protein 3 beta (MIP-3 beta /ELC/CCL19) ELISA Kit 大鼠巨噬细胞炎性蛋白3β(MIP-3β/ELC/CCL19)ELISA试剂盒
贝壳杉烯,,三醇 HPLC≥98% 5mg Rat macrophage inflammatory protein 5 (MIP-5) ELISA Kit 大鼠巨噬细胞炎症蛋白5(MIP-5)ELISA试剂盒
羟基浆果赤霉素 III HPLC≥98% 5mg Rat macrophage migration inhibitory factor (MIF) ELISA Kit 大鼠巨噬细胞移动抑制因子(MIF)ELISA试剂盒
甲氧基羰基beta咔啉 HPLC≥98% 5mg Rat maix metalloproteinase 1 (MMP-1) ELISA Kit 大鼠基质金属蛋白酶1(MMP-1)ELISA试剂盒
脱羧氧代茶酸 HPLC≥98% 5mg Rat maix metalloproteinase 10 (MMP-10) ELISA Kit 大鼠基质金属蛋白酶10(MMP-10)ELISA试剂盒
乙酰基掬万寿局素 A HPLC≥98% 5mg Rat maix metalloproteinase 13 (MMP-13) ELISA Kit 大鼠基质金属蛋白酶13(MMP-13)ELISA试剂盒
,贝壳杉烷二醇 HPLC≥98% 5mg Rat maix metalloproteinase 2/ gelatinase A (MMP-2/Gelatinase A) ELISA Kit 大鼠基质金属蛋白酶2/明胶酶A(MMP-2/Gelatinase A)ELISA试剂盒
,,三羟基齐墩果烯酸 HPLC≥98% 5mg Rat maix metalloproteinase 3 (MMP-3) ELISA Kit 大鼠基质金属蛋白酶3(MMP-3)ELISA试剂盒
,,三邻甲基鞣花酸 HPLC≥98% 5mg Rat maix metalloproteinase 4 (MMP-4) ELISA Kit 大鼠基质金属蛋白酶4(MMP-4)ELISA试剂盒
,脱氢维酮 HPLC≥98% 5mg Rat maix metalloproteinase 7 (MMP-7) ELISA Kit 大鼠基质金属蛋白酶7(MMP-7)ELISA试剂盒
金色隐球酵母直销Rat macrophage inflammatory protein 3 alpha (MIP-3 alpha /CCL20) ELISA Kit 大鼠巨噬细胞炎性蛋白3α(MIP-3α/CCL20)ELISA试剂盒 脱氧尤可甾醇 HPLC≥98% 5mg
Rat macrophage inflammatory protein 3 beta (MIP-3 beta /ELC/CCL19) ELISA Kit 大鼠巨噬细胞炎性蛋白3β(MIP-3β/ELC/CCL19)ELISA试剂盒 异海松烯,二醇 HPLC≥98% 5mg
Rat macrophage inflammatory protein 5 (MIP-5) ELISA Kit 大鼠巨噬细胞炎症蛋白5(MIP-5)ELISA试剂盒 贝壳杉烯,,三醇 HPLC≥98% 5mg
Rat macrophage migration inhibitory factor (MIF) ELISA Kit 大鼠巨噬细胞移动抑制因子(MIF)ELISA试剂盒 羟基浆果赤霉素 III HPLC≥98% 5mg
Rat maix metalloproteinase 1 (MMP-1) ELISA Kit 大鼠基质金属蛋白酶1(MMP-1)ELISA试剂盒 甲氧基羰基beta咔啉 HPLC≥98% 5mg
Rat maix metalloproteinase 10 (MMP-10) ELISA Kit 大鼠基质金属蛋白酶10(MMP-10)ELISA试剂盒 脱羧氧代茶酸 HPLC≥98% 5mg
Rat maix metalloproteinase 13 (MMP-13) ELISA Kit 大鼠基质金属蛋白酶13(MMP-13)ELISA试剂盒 乙酰基掬万寿局素 A HPLC≥98% 5mg
Rat maix metalloproteinase 2/ gelatinase A (MMP-2/Gelatinase A) ELISA Kit 大鼠基质金属蛋白酶2/明胶酶A(MMP-2/Gelatinase A)ELISA试剂盒 ,贝壳杉烷二醇 HPLC≥98% 5mg
Rat maix metalloproteinase 3 (MMP-3) ELISA Kit 大鼠基质金属蛋白酶3(MMP-3)ELISA试剂盒 ,,三羟基齐墩果烯酸 HPLC≥98% 5mg
Rat maix metalloproteinase 4 (MMP-4) ELISA Kit 大鼠基质金属蛋白酶4(MMP-4)ELISA试剂盒 ,,三邻甲基鞣花酸 HPLC≥98% 5mg
公司优势:
☆销售方面,公司已有多年的销售经验,早已形成一套完整的产销链条,在业内是有口皆碑的;
☆技术背景,我司是专业的生物技术公司,拥有一批专业技术人才和技术设备,专业实力雄厚;
☆主营产品,我司主打ELISA试剂盒代理各种世界品牌的细胞、菌株、抗体、培养基、血清以及其他生化试剂等各方面的生物试剂,种类齐全,数量繁多,能满足生命领域里的不同科研需求;
☆公司理念,公司秉承质量为上、诚信经营的理念。
风险提示:丁香通仅作为第三方平台,为商家信息发布提供平台空间。用户咨询产品时请注意保护个人信息及财产安全,合理判断,谨慎选购商品,商家和用户对交易行为负责。对于医疗器械类产品,请先查证核实企业经营资质和医疗器械产品注册证情况。
 文献和实验
文献和实验新生隐球菌及其检验是微生物检验考试复习需要了解的知识,医学|教育网搜集整理了相关内容与考生分享。 新生隐球菌(CuyitococcusNeofonmans)又名溶组织酵母菌(TorulaHistolytica),是土壤,鸽类,牛乳、水果等的腐生菌,也可存在人口腔中,可侵犯人和动物,一般为外源性感染,但也可能为内源性感染,对人类而言,它通常是条件致病菌。 本菌在组织液或培养物中呈较大球形,直径可达5-20um,菌体周围有肥厚的荚膜,折光性强,一般染料不易着色难以发现,称隐球菌,用墨汁阴性
新生隐球菌及其检验是微生物与寄生虫检验考试复习需要了解的知识,医学|教育网搜集整理了相关内容与考生分享。 新生隐球菌(CuyitococcusNeofonmans)又名溶组织酵母菌(TorulaHistolytica),是土壤,鸽类,牛乳、水果等的腐生菌,也可存在人口腔中,可侵犯人和动物,一般为外源性感染,但也可能为内源性感染,对人类而言,它通常是条件致病菌。 本菌在组织液或培养物中呈较大球形,直径可达5-20um,菌体周围有肥厚的荚膜,折光性强,一般染料不易着色难以发现
新型隐球菌(Crytococcus Neofonmans )又名溶组织酵母菌(Torula Histolytica ),是土壤,鸽类,牛乳、水果等的腐生菌,也可存在人口腔中,可侵犯人和动物,一般为外源性感染,但也可能为内源性感染,对人类而言,它通常是条件致病菌。 本菌在组织液或培养物中呈较大球形,直径可达5-20um,菌体周围有肥厚的荚膜,折光性强,一般染料不易着色难以发现,称隐球菌,用墨汁阴性显影法镜检,可见到透明荚膜包裹着菌细胞
 技术资料
技术资料暂无技术资料 索取技术资料










